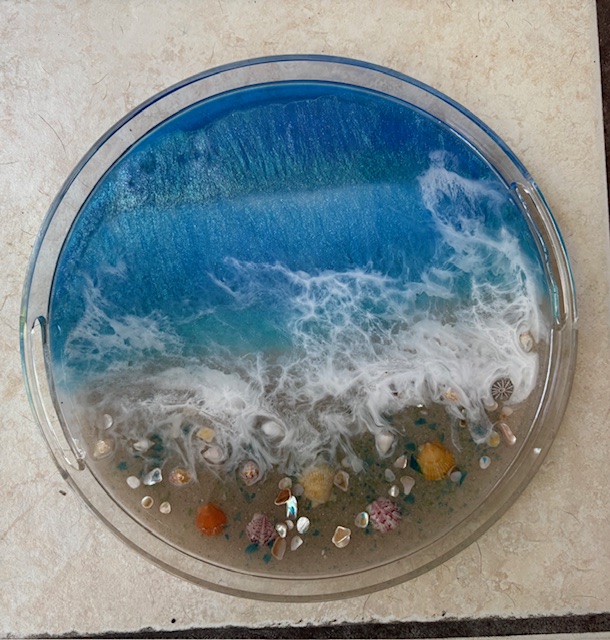
My resin piece

This holiday season, I’ve been working on pulling myself out of (yet another) negative spiral. These days, I can usually pinpoint the combination of events that sparks the spiral. Unfortunately, knowing the triggers has not yet stopped the beginning (or continuation) of the spiral. Awareness of triggers is the first step and I need to keep working on halting the spiral before it starts. But the past couple of weeks I’ve been working on stopping one I’m in, with a focus on the holiday things that bring me joy. Because “Tis the season”.
A line from a blog post from Everyday Gyaan really made me think about this season a bit different. [ Link here ]. She said, “Not every season is meant for growth that can be measured or displayed. Some seasons are meant only for survival and care”. And so, this season I focused on the everyday things that bring me joy, to try and just breathe through the triggers and survive.
I don’t usually do photo-heavy blog posts, as I’m not a regular picture taker. However, as part of the stop this spiral, I did engage in a number of holiday activities and took some pictures along the way!
Lights, lights, and more lights. I really do enjoy Christmas lights. This year, I forced hubby to participate in not one, not two, but 5 viewings of various light displays in two weeks. We did Florida Botanical Gardens after-dark lights, the downtown St Petersburg bay-front parks, a lighted holiday boat parade, walking through a well-lit local park after dark (Largo Central Park), and a drive-through a local neighborhood known for its light displays.





Holiday music. Yes, I am one of those who really does love Christmas music! I put a holiday music station on my car radio right after Thanksgiving and have been singing along when I’m alone in the Jeep. It helped as I realized that I lost all my Christmas CDs (and CD player) in the flood. We also stopped to listen to various music presentations during our botanical garden walk, went to a “Broadway Christmas” concert (hubby rolled his eyes for most of that one), and saw a wonderful musical rendition of A Christmas Carol.
Holiday gatherings with friends. I had more holiday gatherings than I had holiday shirts to wear! Both garden clubs had holiday lunches and one book club had our annual gathering with significant others (and a fun book exchange). There was a lovely ornament exchange brunch; a solo road trip to Naples for a girlfriend visit; and a enjoyable Christmas Eve dinner. These gatherings reinforced the friend’s support I do have around me.
There was also a cardio drumming glow party, a resin workshop with friends, seeing the Wicked movie, and a few lunches and dinners out. And yet, I also felt there was down-time, do nothing time, and breathing time. I spent time thinking about the up-coming year (what to let go, where to focus), and contemplating a Word of the Year.

The focus on everyday things helped me make it through a challenging holiday season. Challenges came with missing some of our old family traditions for the holidays. I had also hoped to see more house progress by now. And there are conflicting feelings as I do my end-of-year contemplation about where do I really want to spend my time and energy. But keeping the focus on holiday lights, music, and friends’ gatherings was the best thing to care for myself.
Do you love (or tolerate) the lights, music, and social gatherings of end of year holiday season?
Copyright © 2025 retirementtransition.blog – All rights reserved.

I enjoy the holiday period of Thanksgiving and Christmas but am ready to pack it all up and get back to normal as soon as it’s over. We finished packing up our Christmas decorations and tree yesterday and hope to get it back stored in the attic today. Every year it is a lot of work and I wonder why we do so much.
Happy New Year!
LikeLiked by 1 person
When I’ve done the holiday decorations (some years we didn’t because we did the snowbird and left day after Christmas to head to Florida!), I’ve kept them up till the Epiphany. I’m looking forward to doing that next year actually… although I’ve looked at the blueprint for our new house and wondered, where are we going to put the tree! And we lost all the bushes and trees we put lights on… maybe by November I’ll have new ones? But I can understand a desire to clean it all up and get back to a more normal. I’m looking forward to our subcontractors getting back to normal work days for sure!
LikeLike
Glad the lights and music of the season have brought you joy. Hopefully with the new year, your new home builder will make great strides on your house.
LikeLiked by 1 person
It was a quiet holiday but I did enjoy our excursions to to see the lights. I need to keep focusing on those small moments of joy!
LikeLike
Pat, it sounds like you had a fun and festive December. Thanks for sharing some photos in this post. You know how much I love photos…almost as much as I love Christmas lights. Happy New Year!
LikeLiked by 1 person
Suzanne, You always have amazing photos! I was a bit embarrassed to share my a quick take one and move on ones, but I did it. It was fun to look back on all the fun activities I forced hubby to do for the holiday. It was festive… and now on to the new year and all it holds going forward. Happy New Year to you & yours!
LikeLiked by 1 person
Pat, photos are personal, to your life and your interests. What you share is totally up to you. But, as beautifully as you write, words don’t always tell the story. I am a terrible writer, but a decent photographer, so I tell my story differently. It’s all about connecting, in whatever way we can. I’m looking forward to your next chapter.
LikeLiked by 1 person
I love Christmas lights! Although we don’t have any outdoor lights, many people in town really go big and I love driving through at night to see them all. I make it a point to turn my tree on every morning until I leave the house and again when I get home.
Thanks for the pictures and I hope you have a Happy New Year.
LikeLiked by 1 person
We took our town park lights down yesterday (one of my volunteer organizations) and it was kinda sad knowing all the lights will be coming down. I do like how everything looks with the holiday lights! Happy New Year to you!
LikeLiked by 1 person
And same to you!
LikeLike
I like a bit of Christmas. I love Christmas lights and would never get bored regardless I don’t celebrate Christmas anymore. (I just take Christmas as relaxation time.)
My Christmas’s are mostly quiet. There is no other family but me. But I like quiet and not the busyness of Christmas.
LikeLiked by 1 person
Liz, I too (tried to) appreciate the quiet of Christmas this year. I took time to just be, to read quite a bit and to think about what I want the year ahead to be like. It was actually nice to not be busy!
LikeLiked by 1 person
Lovely. 😊
LikeLike
Hi Pat – good on you for stepping up your Christmas game and being so intentional about appreciating the joy that comes with the season. I love the lights and music too – and I understand how you would also miss some of those little traditions that the flood stole from you. We’ve just waved goodbye to our kids and grandgirls and are sitting in the silence feeling at peace with the world. It really is a wonderful time of the year. I’ll see you in January with our new Words. x
LikeLiked by 1 person
Leanne, it’s interesting as I’m responding to comments (I need to get a better handle of when to do that in my weekly schedule), that you used the word intentional! You’ll see in this weeks post… that’s my final chosen WOTY! Fascinating how you seemed to sense it. Looking forward to reading about your WOTY!
LikeLike
Your seashore resin is absolutely gorgeous!! Is that a serving platter? Glow stick drumming! That sounds like something that needs to happen at least once a month. I LOVE Christmas lights!! It’s part of why I find it sad to come to Florida in December. Certainly at the condo complex, almost no one does Christmas lights. My daughter in Charleston SC agrees southerners just don’t do home Christmas light decorations like back in Cincinnati.
LikeLiked by 1 person
Thanks for the compliment on the resin piece; it’s a lazy susan server. My new-to-be kitchen has a deep corner, so I though I could put it there with some things I use frequently. But Tim’s says that will cover it up too much.
It’s interesting your take on lights. I think it’s a but hit and miss here as so many folks in our area are snowbirds and just don’t have the holiday stuff anymore. I’ve found that the older “real Florida” neighborhoods actually have as many lights as we had in our Cincinnati neighborhoods. My beach neighborhood even has a contest and awards prizes for best houses lit up! Two years ago, Tim tried but wasn’t even in competition. Next year I expect him to do it again. He likes that he can put up lights (and take them down) without it being cold! Happy New Year!
LikeLiked by 1 person
I agree. I think the percent of snowbirds/rentals would make a big difference in decorating.
LikeLike